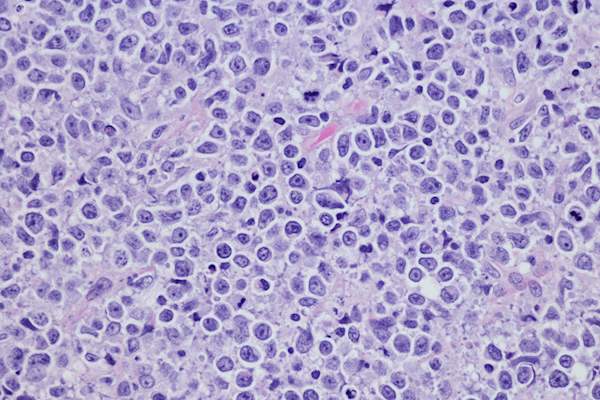

非霍奇金淋巴瘤:识别症状


非霍奇金淋巴瘤NHL是一种始于白细胞淋巴细胞的癌症,淋巴细胞是人体免疫系统的一部分。这种癌症最常发生在成年人身上,但也可能发生在儿童时期。NHL通常开始于淋巴结或其他淋巴组织,并可扩散到皮肤和其他器官,包括骨髓、胸腺、腺样体、扁桃体、脾脏和消化道。

其他常见的NHL症状
额外的症状可能包括寒战、体重减轻、疲劳、腹部肿胀、小餐后饱腹感、胸痛或压痛、呼吸短促或咳嗽、严重或频繁的感染,以及容易出血或淤青。请记住,其中许多症状也可能是其他病症的征兆。

腹部NHL症状
当淋巴瘤在腹部生长时,它会引起腹部肿胀和疼痛。这可能是由于肿大的淋巴结,肿大的脾脏或肝脏,或积液引起的。脾脏会压在胃上,导致食欲不振,甚至在小餐后也会有饱腹感。胃或肠的淋巴瘤会引起疼痛、恶心或呕吐。

胸部有NHL
如果淋巴瘤生长在胸腺或淋巴结,它会压迫胸腔内的气管,引起咳嗽、呼吸困难、胸压或疼痛。如果它压迫上腔静脉(SVC),一个负责将血液从头部和手臂输送到心脏的大静脉,血液就会回到静脉中。这会导致呼吸困难、肿胀以及头部、手臂和胸部上部的蓝色色调。SVC综合症可以危及生命。

脑和脊髓中的NHL
中枢神经系统淋巴瘤这种症状很少见,可导致恶心、呕吐、头痛、精神混乱、四肢无力或脸部无力,甚至癫痫发作。如果淋巴瘤扩散到大脑或脊髓周围区域,它会导致复视、面部无力、听力丧失、说话困难、行走困难或一侧身体瘫痪。
症状可能因传播速度而异
虽然不是硬性规定,懒惰的或生长缓慢的淋巴瘤可能需要一段时间才能引起任何症状侵袭性淋巴瘤可能生长得更快,并迅速引起症状。无论淋巴瘤生长得多快,它都能扩散到淋巴系统的其他部分或身体的某些部位,如肝脏、大脑或骨髓。

B症状:全身性,更严重
也有一组二级或"B症状“对于非霍奇金淋巴瘤,包括不是由感染引起的持续数天或数周的发烧;夜间盗汗;以及突然、显著的体重减轻(六个月内体重减轻10%或更多)。B型症状可能提示恶性淋巴瘤;如果你遇到这种情况,你应该立即去看医生。

可能不是淋巴瘤
前几张幻灯片中描述的许多症状也可能与其他不太严重的健康状况或其他癌症有关。当你经历任何无法解释的症状并持续存在时,尤其是如果你的家族中有淋巴瘤病史或你有淋巴瘤病史时,向你的医生进行检查是很重要的风险因素的疾病。早期诊断至关重要。